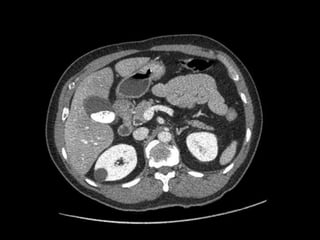

O documento resume as principais características da vesícula biliar e algumas de suas variantes e condições patológicas. Em três frases:
A vesícula biliar é uma bolsa localizada na face inferior do fígado que armazena a bile produzida pelo fígado. Pode apresentar variantes como duplicação, septos internos ou localização anômala, e estar sujeita a condições como colecistite aguda ou enfisematosa quando inflamada. A TC e a US são as modalidades de imagem mais usadas para aval